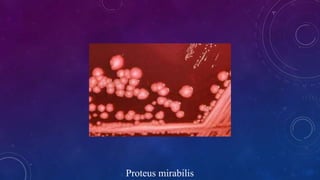
Proteus mirabilis

O documento trata das bactérias das famílias Enterobacteriaceae, Vibrionaceae, Bacillus e Clostridium, detalhando suas características, patogenicidade e infecções que podem causar. Especificidades como mecanismos de defesa, estrutura antigênica e exemplos de espécies de cada família, como E. coli e Klebsiella pneumoniae, são abordadas. Além disso, há uma menção às infecções mais comuns e aos riscos para a saúde humana associados a essas bactérias.